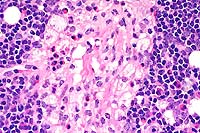

Results
AFIP Wednesday Slide Conference - No. 11
November 25, 1998
- Conference Moderator: Dr. F. Yvonne Schulman
Diplomate, ACVP
Department of Veterinary Pathology
Armed Forces Institute of Pathology
Washington, DC 20306-6000
NOTE: Click on images for larger views. Use browser's
"Back" button to return to this page.
Return to WSC Case Menu
-
- Case I - 6122-98 (AFIP 2636443)
-
- Signalment: Tissue from an eight-year-old, neutered,
male Italian greyhound.
-
- History: The dog had an acute onset of mild to moderate
ataxia involving all four limbs. Continued decline in the face
of corticosteroid and lamustine therapy resulted in euthanasia
about 10 weeks later.
-
- Gross Pathology: An increased amount of fleshy tan
tissue was evident on the dorsal aspect of the medulla oblongata,
extending down along the external dorsal surface of the cervical
spinal cord. Sections through this area into the adjacent brain
revealed extension of this tissue into the parenchyma grossly,
blurring architectural landmarks. Less obvious, ill-defined discoloration
was evident in other regions of the brain. The ventricular system
was severely dilated.
Laboratory Results: Spinal fluid analysis identified a
protein content of 70 mg/dl and a total nucleated cell count
of 45/ml. The cells were predominantly mononuclear; some appeared
atypical. MRI revealed marked and irregular contrast enhancement
in the brain stem, cerebellum and medial to each lateral ventricle.
-
- Contributor's Diagnosis and Comments: Round cell sarcoma,
possibly rhabdoid tumor.
-
- Although the submitted specimens contain a single grossly
visible lesion, there were additional areas of neuropil involvement
that were generally peripheral in location involving the brain
from the meningeal space inwards. Because extra-neural tissues
were not submitted, the extent of somatic involvement, such as
might occur in some round cells tumors, could not be defined.
This patient is relatively old compared to patients with rhabdoid
tumors described in the literature. Although the histological
appearance and multifocal localization are suggestive of rhabdoid
tumor, myeloproliferative disease, lymphosarcoma, histiocytosis,
and plasma cell tumor should be considered as differentials.
-
- Plasmacytoma has been recently reported in a single adult
dog with a similar pattern of lesions. A case of myelocytic leukemia
had more extensive peripheral nervous system involvement and
an abnormal peripheral blood smear. There was no indication of
abnormal hemogram in this patient, but some possibility of neoplastic
cells was evident in the cerebrospinal fluid (the slide is no
longer available for examination). Individual cell morphology
is more varied and atypical than that usually associated with
nervous system lymphoma or microglioma. Immunohistochemical staining
and electron microscopic examination might help in better establishing
the diagnosis.
 10x
obj
10x
obj
- Case 11-1. Spinal cord. A densely cellular neoplasm
effaces normal neuropil.
 40x
obj
40x
obj
- Case 11-1. Spinal cord. Neoplastic cells have pleomorphic
nuclei, anisocytosis, and mitotic figures.
-
- AFIP Diagnosis: Brain stem: Malignant pleomorphic
round cell tumor, favor T-cell lymphoma, Italian greyhound, canine.
-
- Conference Note: A poorly differentiated neoplasm
effaces portions of the brain stem and infiltrates the meninges
and subpial parenchyma. The neoplasm is composed of highly pleomorphic
round cells. Neoplastic cells multifocally occur within Virchow-Robins
space in less affected areas of the brainstem, and there are
perivascular inflammatory infiltrates both within the tumor and
less affected areas of neuropil. Neoplastic cells are characterized
by variably-distinct cell borders with abundant, eosinophilic
cytoplasm which is occasionally vacuolated or contains phagocytized
cells or debris. There is marked variation in nuclear size and
shape.
-
- The differential diagnosis compiled by conference participants
for this poorly differentiated neoplasm was somewhat similar
to that mentioned by the contributor and included histiocytic
sarcoma, malignant lymphoma, meningeal sarcomatosis, undifferentiated
astrocytoma, rhabdoid tumor, meningioma, and melanoma. In the
absence of immunohistochemical studies, conference participants
generally favored the diagnosis of a poorly differentiated round
cell neoplasm of histiocytic or lymphoid origin.
- A few attendees considered a rhabdoid tumor, but most did
not identify microscopic features described for this neoplasm.
Rhabdoid tumors are typically composed of a monomorphic population
of deceptively bland polygonal cells which contain globoid, eosinophilic
cytoplasmic inclusions and eccentric, round to oval to reniform
nuclei. Rhabdoid tumors in humans typically occur in young children
or juvenile individuals and are highly aggressive. The single
case report of rhabdoid tumor in a dog was also in a young animal
(18 months old). While an atypical variant of human rhabdoid
tumor has been described in children, cells of these neoplasms
maintain some degree of "rhabdoid" morphology.
-
- Immunohistochemically, neoplastic cells in the tumor of this
Italian greyhound are negative for glial fibrillary acidic protein,
lysozyme, pan-cytokeratin, synaptophysin, CD45RA and CD79a. Tumor
cells stained positively for CD3 and CD30; scattered cells were
positive for vimentin. The diagnosis of malignant pleomorphic
round cell tumor, favor T-cell lymphoma, is based on histomorphology,
immunohistochemical results, and consultation with the Departments
of Hematopathology and Neuropathology.
-
- This canine neoplasm shares several histologic and immunohistochemical
similarities described for a variant of human lymphoid malignancy
known as anaplastic large cell lymphoma (ALCL). A relatively
rare malignant neoplasm of Null T-cell types, the tumor is histologically
characterized by large blastic round cells which may grow in
a cohesive pattern and contain pleomorphic, sometimes horsehoe-shaped
or multiple nuclei with prominent nucleoli. Tumor cells are usually
strongly positive for CD30, and this finding coupled with the
presence of large, anaplastic lymphoid cells make this tumor
a distinct clinicopathologic entity among human lymphomas. There
may be a variable admixture of granulocytes and macrophages within
the tumor, and a lymphohistiocytic variant also occurs. Many
cases of ALCL were previously diagnosed as malignant histiocytic
tumors, regressing atypical histiocytosis, metastatic melanoma,
sarcoma, or carcinoma.
Contributor: Veterinary Medical Diagnostic Laboratory,
University of Missouri, P.O. Box 6023, Columbia, MO 65205.
-
- References:
- 1. Steele KE, Schulman FY, Mena H, Strimple EO: Rhabdoid
tumor in the brain of a dog. Vet Pathol 34:359-363, 1997.
- 2. Sheppard BJ, Chrisman CL, Newell SM, Raskin RE, Homer
BL: Primary encephalitic plasma cell tumor in a dog. Vet Pathol
34:621-627, 1997.
- 3. Christopher MM, Metz AL, Klausner J, Polzin D, Hayden
DW: Acute myelomonocytic leukemia with neurologic manifestation
in the dog. Vet Pathol 23:140-147, 1986.
- 4. Benko l: A case of reticulum cell sarcoma in the brain
of a dog. Vet Rec:100-101, 26 Jul 1969.
- 5. Rubenstein LJ: Tumors of the Lymphoreticular System. In:
Tumors of the Central Nervous System, pp. 215-234, Armed Forces
Institute of Pathology, Washington DC, 1972.
- 6. Burger PC, et al.: Atypical teratoid/rhabdoid tumor of
the central nervous system: A highly malignant tumor of infancy
and childhood frequently mistaken for medulloblastoma. Amer J
Surg Pathol 22:1083-1092, 1998.
- 7. Harris NL, et al.: A revised European-American classification
of lymphoid neoplasms: A proposal from the international lymphoma
study group. Blood 84(5):1361-1392, 1994.
-
- Case II - 97P12580 (AFIP 2643798)
-
- Signalment: Two-week-old, Salers crossbred, male,
bovine (Bos taurus).
-
- History: The calf was unable to stand from the time
of birth. Physical examination revealed a slightly domed skull,
bobbing and weaving of the head when not being rested on the
floor or against the body, ventral rotation of the eyes, oscillating
nystagmus, and the maxilla was shorter than the mandible.
-
- Gross Pathology: The thyroid gland was enlarged (1.5X)
and greenish-brown with several black foci about 0.5 cm in diameter.
The kidneys were enlarged (1.5X) and greenish-tan. The brain
had a green tint with reduced prominence of white matter, and
mild hydrocephalus.
- Laboratory Results: The hemogram was unremarkable.
-
- Contributor's Diagnosis and Comments:
- Neuronal cell bodies and neurites throughout the brain were
swollen, pale and foamy or vacuolated. The neuronal changes were
more prominent in the thalamus and cerebrum than in the caudal
brain stem. Fine neuropil vacuolation was especially common in
the cerebral gray matter near the gray-white interface and in
the cerebellar Purkinje cell layer. Swollen, pale, foamy or vacuolated
cells also were found in ganglia of all organs, pars nervosa
of the pituitary, lymph nodes, thymic cortex, thyroid follicular
lining cells, adrenal glands, bile ducts and Kupffer cells, and
renal tubular cells.
 20x
obj?
20x
obj?
- Case 11-2. Cerebrum. Diffusely, neurons are expanded
by clear cytoplasmic vacuoles. There are also moderately increased
numbers of astrocytes, with clear cytoplasm.
-
- The owner had used pasture breeding on the herd of 70 cows.
A Salers bull had been in use for three years and a Braunvieh
for two years. Some heifers were kept as herd replacements. Last
year, there was one affected calf, but it was not presented for
necropsy. This year, there were five affected calves, and two
were presented for necropsy. Blood samples from this affected
calf, its dam and both bulls were submitted to the Michigan State
University Molecular Pathology Laboratory for DNA analysis. The
beta mannosidosis mutation is a single base pair change. The
calf, dam and Salers bull were positive for the mutant DNA.
 2x
obj
2x
obj
- Case 11-2. Lymph Node. Foamy histiocytic cells efface
and replace normal nodal architecture.
 40x
obj
40x
obj
- Case 11-2. Lymph node. Foamy macrophages replace lymphoid
cells. Rare neutrophils and eosinophils are also present.
- AFIP Diagnosis: Lymph node: Histiocytosis, diffuse,
moderate, with intrahistiocytic vacuoles, Salers crossbred calf,
bovine.
-
- Conference Note: Beta-mannosidosis in Salers cattle
is a rapidly fatal, inherited autosomal recessive lysosomal storage
disease which results in the accumulation of oligosaccharides
and subsequent cytoplasmic vacuolation in neurons, tubular epithelial
cells, thyroid follicular cells, and macrophages of nervous,
renal, thyroid, and lymphoid tissues. Deficiency of b-mannosidase
results in accumulation of disaccharide and trisaccharide with
a terminal mannose b-linked to N-acetyl-glucosamine. The disease
has also been reported in humans and in Anglo-Nubian goats.
-
- Clinical signs in affected Salers calves include weakness,
fine head tremor which becomes exacerbated by movement, occasional
opisthotonus, and ventromedial rotation of the eyes and/or intermittent
ocular oscillations while in lateral recumbency. Gross pathological
findings often include dome-shaped calvarium, brachygnathism,
atrophy of the brain with hydrocephalus, and enlargement of the
kidneys, liver, lymph nodes, and thyroid gland. The most significant
microscopic finding is marked cytoplasmic vacuolation of multiple
cell types, with nervous, renal, thyroid, and lymphoid tissues
being the most severely affected.
-
- Beta-mannosidosis causes acute, severe demyelination in the
brain of affected calves, and this is important in distinguishing
this disease from other bovine storage diseases. Inherited a-mannosidosis,
a more economically important storage disease of Angus, Murray
Grey and Galloway cattle, causes a mild demyelinating lesion
which tends to occur later in the course of the disease. Acquired
a-mannosidosis of herbivores may also occur secondary to ingestion
of toxic plants from the genera Swainsona, Oxytropis, and Astragalus.
Bovine GM1 gangliosidosis of Friesian cattle causes gliosis and
demyelination in the terminal stages of disease. Type II glycogenosis
in Brahman cattle does not cause significant demyelinating lesions
in the white matter of the brain.
-
- While signalment, history, clinical signs, gross and histologic
findings are useful indicators in suspect cases of b-mannosidase
deficiency, definitive diagnosis of the disease relies on genetic
analysis and/or measurement of plasma b-mannosidase activity
of affected calves and genitors. Conference participants noted
that hyperlipidemia may cause accumulation of high numbers of
vacuolated macrophages in various tissues, and was considered
in the differential diagnosis for the microscopic findings in
this lymph node.
-
- Contributor: Department of Veterinary Pathology, Iowa
State University, Christiansen Drive, Ames, IA 50011.
-
- References:
- 1. Bryan L, Schmutz S, Hodges SD, Snyder FF: Bovine b-mannosidosis:
Pathologic and genetic findings in Salers calves. Vet Pathol
30:130-139, 1993.
- 2. O'Toole D, Welch V, Redland K, Williams ES: Ubiquitinated
inclusions in brains from Salers calves with b-mannosidosis.
Vet Pathol 30:381-385, 1993.
- 3. Cavanagh KT, Jones MZ, Abbitt B, Skinner R: Bovine plasma
b-mannosidase activity and its potential use for b-mannosidosis
carrier detection. J Vet Diagn Invest 4:434-440, 1992.
- 4. Jolly RD, Walkley SU: Lysosomal storage diseases of animals:
An essay in comparative pathology. Vet Pathol 34:527-548, 1997.
-
- Case III - 98-3956 (AFIP 2642345)
-
- Signalment: The patient was a nine-month-old, female,
Himalayan cat.
-
- History: The cat had a swollen lip one week prior
to presentation at an emergency clinic. This was treated with
a 20mg injection of Depo-Medrolä. The owners felt since
that point the cat slowed down and was sleeping a lot. The cat
was presented to the emergency clinic prostrate and gasping,
with cyanotic mucous membranes and clear fluid exuding from the
nose. The cat had a grade III holosystolic murmur, was hypotensive,
and died within 10 minutes of arrival.
-
- Gross Pathology: The cat was an intact, female, blue
point Himalayan weighing 3.1 kilograms. The mucous membranes
were pale and cyanotic, and blood-tinged fluid was present around
the nares and in the pharynx. The lungs were heavy, wet, and
exuded fluid on cut surface. The heart was small, pale, and weighed
18 grams. The endocardial surface was tan/white, and there were
hemorrhages on the epicardial surface and around the coronary
veins. A few, patchy hemorrhages were also present on the endocardial
surface. The stomach contained cat food, the intestine had a
small amount of fluid contents, and the colon had formed stool.
-
- Laboratory Results: Routine cultures of lung were
negative for microorganisms.
-
- Contributor's Diagnosis and Comments: Endomyocardial
fibrosis with hemorrhage (restrictive cardiomyopathy).
This appeared to be an unusual form of cardiomyopathy, and the
only references were linked to hypereosinophilic syndromes. However,
this cat did not have evidence of eosinophilic infiltrates in
any organ. This may reflect the prior injection of corticosteroids.
The cat was a "show cat" and appeared relatively normal
until the week before its death. Yet, the myocardial lesions
were extensive and severe, with involvement of papillary muscles
as well as both ventricles. The lesions were more extensive in
the left ventricle, but were present throughout the heart. Some
sections contain papillary muscle, while other sections extend
into dilated atria.
 4x
obj
4x
obj
- Case 11-3. Heart. Papillary muscle is partly replaced
by adipose (fat) cells, a mixture of inflammatory cells, and
wispy fibrillar basophilic material.
-
- AFIP Diagnosis: Heart: Endomyocarditis, neutrophilic
and lymphoplasmacytic, subacute, diffuse, mild to moderate, Himalayan
cat, feline.
-
- Conference Note: While conference participants carefully
considered the contributor's diagnosis of restrictive cardiomyopathy,
most preferred the one indicated above. Microscopically, the
endocardium and subendocardium of the left ventricle are moderately
expanded by an amphophilic, acellular, fibrillar material (edema)
with low to moderate numbers of neutrophils, lymphocytes, macrophages,
plasma cells, and fewer reactive fibroblasts and hemorrhage.
Multifocally within in the epicardium there is mild hemorrhage.
Some of the submitted slides contain sections of right ventricle,
with minimal microscopic change. A Masson's trichrome stain demonstrated
minimal amounts of endocardial collagen.
-
- Conference participants agreed that the clinical history
and microscopic lesions in the heart of this cat are most consistent
with the recently described syndrome of feline endomyocarditis
(EMC)5. Histologic lesions in cats with EMC include varying degrees
of endocardial inflammation characterized by infiltrates of neutrophils
and macrophages, and occasionally lymphocytes and plasma cells
with varying amounts of hemorrhage. Lesions primarily involve
the left heart and are most severe in the dorsal septal wall,
though minimal to mild myodegeneration with small numbers of
inflammatory cells may be present in the right ventricle. Interstitial
pneumonia occurs frequently in cats diagnosed with EMC. Left
ventricular endocardial fibrosis (LVEF) is thought to be a chronic
sequela of EMC based upon the predilection of the left ventricular
outflow tract in both diseases and the gradation of microscopic
lesions with respect to the type of inflammation and amount of
fibrosis.
-
- Affected cats with EMC are most often young (less than 4
years), frequently present to the attending veterinarian with
signs of respiratory distress and rarely hindlimb paresis, and
often have a history of some stressful event within the preceding
three months. Examples of such stressful events include neutering,
declawing, or vaccination, cystitis, boarding and/or grooming,
movement to a new house, and loss or acquisition of another cat
in the household. There is no apparent breed predilection.
-
- Conference participants did not identify microscopic features
of feline restrictive cardiomyopathy (RCM). Histologic lesions
of RCM include endomyocardial fibrosis, myocardial interstitial
fibrosis, myocyte hypertrophy, and myocardial necrosis. Severe
endomyocardial fibrosis of the interventricular septum, left
ventricular free wall, and atria occurs in advanced cases of
RCM. The clinical, historical, and histopathological findings
in this Himalayan cat are more consistent with EMC. If the cat
had survived, this lesion may have progressed to LEVF, one of
several idiopathic feline cardiovascular diseases grouped together
clinically as RCM.
-
- Contributor: Central Veterinary Laboratory for Veterinarians,
5645 199th Street, Langley, British Columbia V3A 1H9.
-
- References:
- 1. Saxon B, Hendrick M, Waddle JR: Restrictive cardiomyopathy
in a cat with hypereosinophilic syndrome. Can Vet J 32:367, 1991.
- 2. McEwen SA, Valli VEO, Hulland TJ: Hypereosinophilic syndrome
in cats: A report of three cases. Can J Com Med 49:248-253, 1985.
- 3. Sisson DD, Thomas WP: Myocardial diseases. In: Textbook
of Veterinary Internal Medicine, Ettinger SJ, Feldman EC, eds.,
4th ed., vol. 1, pp. 1020-1022, WB Saunders, Philadelphia, PA,
1995.
- 4. Bonagura JD, Fox PR: Restrictive cardiomyopathy. In: Veterinary
Current Therapy XII, Bonagura JD, Kirk RW, eds., pp. 863-867,
WB Saunders, Philadelphia, PA, 1995.
- 5. Stalis IH, Bossbaly MJ, Van Winkle TJ: Feline endomyocarditis
and left ventricular endocardial fibrosis. Vet Pathol 32:122-126,
1995.
-
- Case IV - 98C 1819 (AFIP 2642054)
-
- Signalment: Four-month-old, Alaskan Husky, male, canine.
-
- History: The owner of a kennel of Alaskan Huskies
used for competitive long-distance sled-dog racing noticed that
a four-month-old, male, 14 kg pup had a high-stepping gait and
difficulty locating his bowl. The dog's condition worsened over
the next 30 days. On presentation, the dog was ambulatory, bright,
alert and responsive. The principal clinical signs were moderate
ataxia and proprioceptive deficits. Laboratory work-up revealed
no significant changes, other than hemorrhage into the cerebrospinal
fluid. The dog's condition deteriorated, and a seizure occurred.
The dog was euthanized. His unfixed head with attached C1 spinal
cord was submitted on ice packs for examination.
-
- Gross Pathology: Bilaterally symmetrical, 5 x 3 mm
areas of malacia were present in the thalamus (see photograph).
Multifocal areas in ventral portions of the cerebellum had thin
folia.

- Case 11-4. Cerebrum. (see description above)
-
- Laboratory Results: None.
-
- Contributor's Diagnoses and Comments:
- 1. Encephalomalacia, severe, bilaterally symmetrical, subacute,
diencephalon.
2. Atrophy, moderate, multifocal, Purkinje and granular cell
layers, with hypertrophy of Bergmann glia, cerebellum.
3. Atrophy, moderate, multifocal, subacute, laminar, cerebrocortical
sulci, with neuronal necrosis and gliosis.
Etiology: Familial Alaskan Husky Encephalopathy ("sled
dog encephalopathy").
Note: Since several blocks were cut for this case, there
is variability in the severity of lesions, particularly in the
presence of cerebellar changes and the degree of malacia in thalamus.
-
- Bilaterally symmetrical gray matter encephalopathies of dogs
were reviewed recently. It is likely that some of these conditions
are inherited. They resemble subacute necrotizing encephalopathy
in children (Leigh's disease), a primary mitochondrionopathy
due to abnormal thiamine metabolism. The condition in children
is inherited as an autosomal dominant trait. Similar encephalopathies
occur in kindreds of Australian cattle dogs, Malinois-crosses,
salukis, bull mastiffs and Alaskan sled dogs.
The principal lesion in this brain is subacute bilaterally symmetrical
malacia in the diencephalon. I have no objective criteria for
establishing whether the cerebellar lesion was abiotrophic or
hypoplastic, but its multifocal distribution and the presence
of gliosis suggest the former. The cerebrocortical lesions may
have been caused (or exacerbated) by hypoxia during convulsions.
These lesions in sulci appear to have occurred at different times,
since some are more acute than others.
-
- Little information has been published to date on the disease
in Alaskan sled dogs, apart from a description in a veterinary
neuropathology text. The disease has been identified in Minnesota,
Alaska and Wyoming. Diagnosis can be made clinically on the basis
of brain scans. The distribution of the malacic "butterfly"
lesions is characteristic. The biochemical basis for the disease
in these dogs is unknown. The owners were not aware of other
cases in their kennel or pedigree. The sire, dam, and a sibling
of the affected dog were healthy at the time of diagnosis.
 4x
obj
4x
obj
- Case 11-4. Cerebrum. There is a poorly defined zone
of cellular loss and vacuolation representing laminar cortical
necrosis.
 40x
obj
40x
obj
- Case 11-4. Thalamus. At this magnification, cellular
loss is much more noticable. Note the central Gitter cell, vacuolar
degeneration, karyorrhectic debris, and scattered microglia (gliosis).
- AFIP Diagnoses:
- 1. Thalamus: Cavitation and necrosis, focally extensive,
with gitter cells and mild gliosis, Alaskan Husky, canine.
2. Cerebral cortex: Necrosis, laminar, focally extensive, with
mild to moderate gliosis.
3. Cerebellum: Purkinje and granular cell loss, multifocal, segmental,
with moderate gliosis.
-
- Conference Note: Histologically, the gray matter of
the thalamus contains a focally extensive, necrotic, cavitary
lesion, with loss of neuropil, replacement by numerous lipid-laden
macrophages, mild gliosis, and mild vascular proliferation. Within
the cerebral cortex there is a focally extensive, laminar area
of necrosis, with vacuolation of the neuropil, and gliosis; endothelial
hypertrophy and hyperplasia are not evident in this area. The
cerebellum exhibits segmental loss of both internal granular
cell layer neurons and Purkinje cells, with associated Bergmann's
gliosis.
-
- The comparison of "Alaskan Husky" or "sled
dog" encephalopathy to the human entity of Leigh's disease
has been based primarily on the distribution of the neurodegenerative
lesions within the brain and is described as extensive, bilaterally
symmetrical cavitation within the diencephalon extending into
the tegmentum of the mesencephalon and hindbrain. The confluence
of the gross cavitary lesions into a butterfly shape (oblique
"V" shape) seems to be a classical feature of Leigh's
disease in humans and is a consistent finding in affected dogs
(BA Summers, personal communication).
-
- An apparently consistent microscopic finding in human brains
with Leigh's disease is prominent vascular endothelial proliferation
with sparing of the neuronal perikarya in the thalamus, and mild
degenerative changes in the neuronal processes and myelin sheaths.
Several sections of brain from affected dogs may need to be examined
microscopically to identify the vascular changes associated with
the canine disease. While capillary endothelial proliferation
can be seen in early stages of the canine disease, this microscopic
feature may become inapparent in lesions in later stages of the
disease. The progression of the disease over a period of one
month to the point of clinical seizures suggests this dog was
euthanized during endstage disease.
-
- The cerebellar changes, characterized by Purkinje cell loss,
gliosis, and granular cell loss can be part of "sled dog
encephalopathy" (BA Summers, personal communication). As
mentioned by the contributor, the cerebrocortical lesions are
likely due to ischemia or hypoxia, and probably resulted from
seizures.
-
- Contributor: Wyoming State Veterinary Laboratory,
1174 Snowy Range Road, Laramie, WY 82070.
-
- References:
- 1. Summers BA, Cummings JF, de Lahunta A: Degenerative diseases.
In: Veterinary Neuropathology, pp. 212-213, Mosby Yearbook, St.
Louis, MO, 1995.
- 2. Brenner O, de Lahunta A, Summers BA, Cummings JF, Cooper
BJ, Valentine BA, Bell JS: Hereditary polioencephalomyelopathy
of the Australian cattle dog. Acta Neuropathol 94:54-66, 1997.
- 3. Duchen LW, Jacobs JM: Nutritional deficiencies and metabolic
disorders. In: Greenfield's Neuropathology, Adams JH, Duchen
LW eds., 5th ed., pp. 847-850, Oxford University Press, New York,
1992.
- 4. Montgomery DL, Storts RW: Hereditary and striatonigral
and cerebello-olivary degeneration of the Kerry blue terrier.
Vet Pathol 20:143-159, 1983.
-
- Ed Stevens, DVM
Captain, United States Army
Registry of Veterinary Pathology*
Department of Veterinary Pathology
Armed Forces Institute of Pathology
(202)782-2615; DSN: 662-2615
Internet: STEVENSE@afip.osd.mil
-
- * The American Veterinary Medical Association and the American
College of Veterinary Pathologists are co-sponsors of the Registry
of Veterinary Pathology. The C.L. Davis Foundation also provides
substantial support for the Registry.
- Return to WSC Case Menu
 10x
obj
10x
obj
 40x
obj
40x
obj
 20x
obj?
20x
obj?
 2x
obj
2x
obj
40x
obj
40x
obj
 4x
obj
4x
obj

 4x
obj
4x
obj
 40x
obj
40x
obj